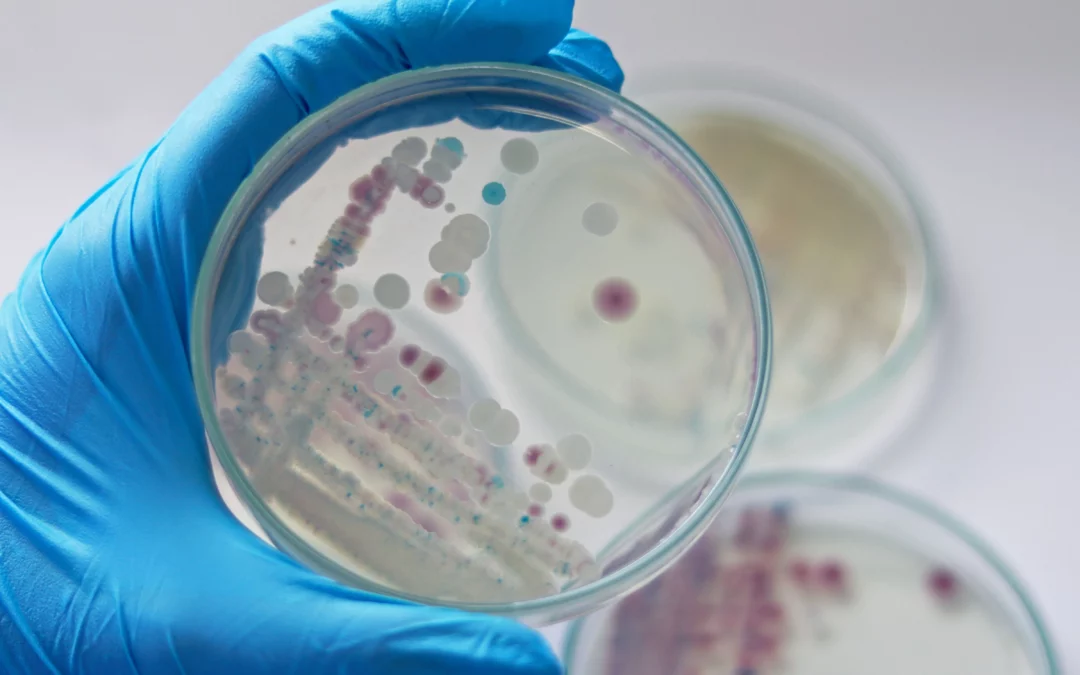
Varias víctimas mortales en EE.UU. por bacteria «comecarne»

Yusmary ha llegado a gastar en agua la mitad del dinero que gana en la semana. Isora acude al mercado negro por cilindros de gas para cocinar. Rodrigo, entre apagones, compró plantas eléctricas para su casa y su negocio. Sálvese quien pueda. Fallas crónicas de los...